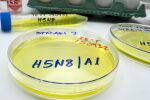
Готова ли е Европа за потенциална заплаха от птичи грип за хората?

Докато вирусът H5N1 продължава да представлява заплаха за селското стопанство и общественото здраве в световен мащаб, учените правят значителни пробиви в разработването на ваксина срещу птичи грип.
Две важни изследвания от САЩ и Великобритания показват обещаващи резултати, които биха могли да променят начина, по който се подготвяме за потенциална пандемия.
Пробив в Университета на Небраска
Иновативен подход за защита на добитъка
Изследователите от Университета на Небраска-Линкълн разработват ваксинационен подход, който демонстрира силна ефикасност при мишки и едър рогат добитък. Проучването, ръководено от вирусолога Ерик Уивър, професор по биологични науки и директор на Небраска Център по вирусология, показа пълна защита срещу тежко заболяване в предклинични модели.
Ваксината срещу птичи грип е проектирана да защитава срещу множество щамове на H5N1 и да генерира имунитет на дихателните пътища, както и в кръвообращението. Този двоен подход е особено важен, тъй като позволява предотвратяване както на разпространението на вируса в тялото, така и пренос на вируса при едър рогат добитък.
Комбинирана стратегия за ваксинация
"Идеята беше, че ако я поставим интрамускулно, можем да предотвратим разпространението ѝ в тялото, а след това мукозният аспект, интраназална ваксина, ще предотврати разпространението от животно на животно", обяснява Уивър.
Телетата са ваксинирани на една седмица възраст чрез комбинация от интрамускулно и интраназално приложение, като получиха бустерна доза четири седмици по-късно. В отделен експеримент ваксинираните мишки са напълно защитени срещу летална инфекция от множество щамове на H5N1.
Първи клинични изпитвания при хора във Великобритания
mRNA технология за бърза реакция
Във Великобритания започват първите клинични изпитвания при хора с ваксина срещу птичи грип, която използва същата mRNA технология като съвременните COVID ваксини. Тази технология позволява бързо създаване и мащабиране на ваксината в случай на пандемия.
Първите доброволци получават ваксината в клиника в Саутхамптън. Клеър Хауърд от Хампшир, която отглежда кокошки от години, е една от първите доброволци:
Мащабни изпитвания с 4000 участници
Мащабното изпитване ще включи 4000 доброволци, като три четвърти ще бъдат набрани в 26 центъра в Англия и Шотландия, а останалите в Съединените щати. Изпитването се насочва към фермери и хора над 65 години, двете най-рискови групи.
Според д-р Ребека Кларк, национален координиращ изследовател на изпитването: "Този щам еволюира и се разпространява сред животинските видове. Въпреки че все още не се предава лесно между хора, трябва да разглеждаме предаването от човек на човек като реална възможност."
Глобалната заплаха от H5N1
Въздействие върху селското стопанство
Вирусът H5N1 нарушава селскостопанските системи в световен мащаб, като е води до умъртвяването на повече от 166 млн. търговски птици в Съединените щати от 2022 г. насам. През 2024 г. вирусът се разпространява при млечни кози, безпрецедентен пренос между видовете и впоследствие причини заболяване при около 70 фермерски работници с близък контакт със заразени животни.
Риск за общественото здраве
От 2024 г. насам има 116 потвърдени случая при хора по света, почти всички свързани с близък контакт със заразени животни. Заплахата за хората в момента е ниска според Агенцията за здравна сигурност на Великобритания, но експертите подчертават важността на пандемичната готовност.
Предимства на mRNA технологията
Бърза адаптация и производство
Традиционният метод за създаване на ваксини срещу грип включва отглеждане на вируса в яйца, което може да бъде проблематично при вирулентни щамове на птичи грип, които могат да убият яйцата, използвани по време на производството.
По време на пандемията COVID-19 mRNA ваксините са силно ефективни в предотвратяването на тежко заболяване и са произведени и променяни бързо, докато щамовете еволюират.
Производствен капацитет
Новият завод в Харуел, Оксфордшир, може да произведе 100 млн. дози ваксина годишно, но в случай на пандемия това може да бъде увеличено до 250 млн. дози.
Финансиране и глобален достъп
Международна подкрепа
CEPI (Коалицията за иновации в подготовката за епидемии) осигурява 40 млн. лири финансиране за изпитването, след като американското правителство намали финансирането за mRNA ваксини с 500 млн. долара.
Като част от споразумението, производителят се задължава да гарантира бърза и достъпна доставка на ваксината до страните с ниски и средни доходи при бъдеща пандемия.
Разработването на ваксина срещу птичи грип с mRNA технология представлява значителен напредък в пандемичната готовност. Комбинирането на американските изследвания при животни с британските клинични изпитвания при хора създава солидна основа за бъдещата защита срещу H5N1.
Въпреки че заплахата за хората остава ниска в момента, проактивният подход на учените може да се окаже от решаващо значение за предотвратяването на следващата пандемия. Успехът на тези изпитвания може да доведе до ефективна защита както за селскостопанските животни, така и за хората, работещи с тях.
Съдържанието е информативно и не представлява консултация, препоръка или съвет. При въпроси относно вашето здраве, медицинско състояние или лечение, задължително се консултирайте с медицински специалист.
------------------------------------------